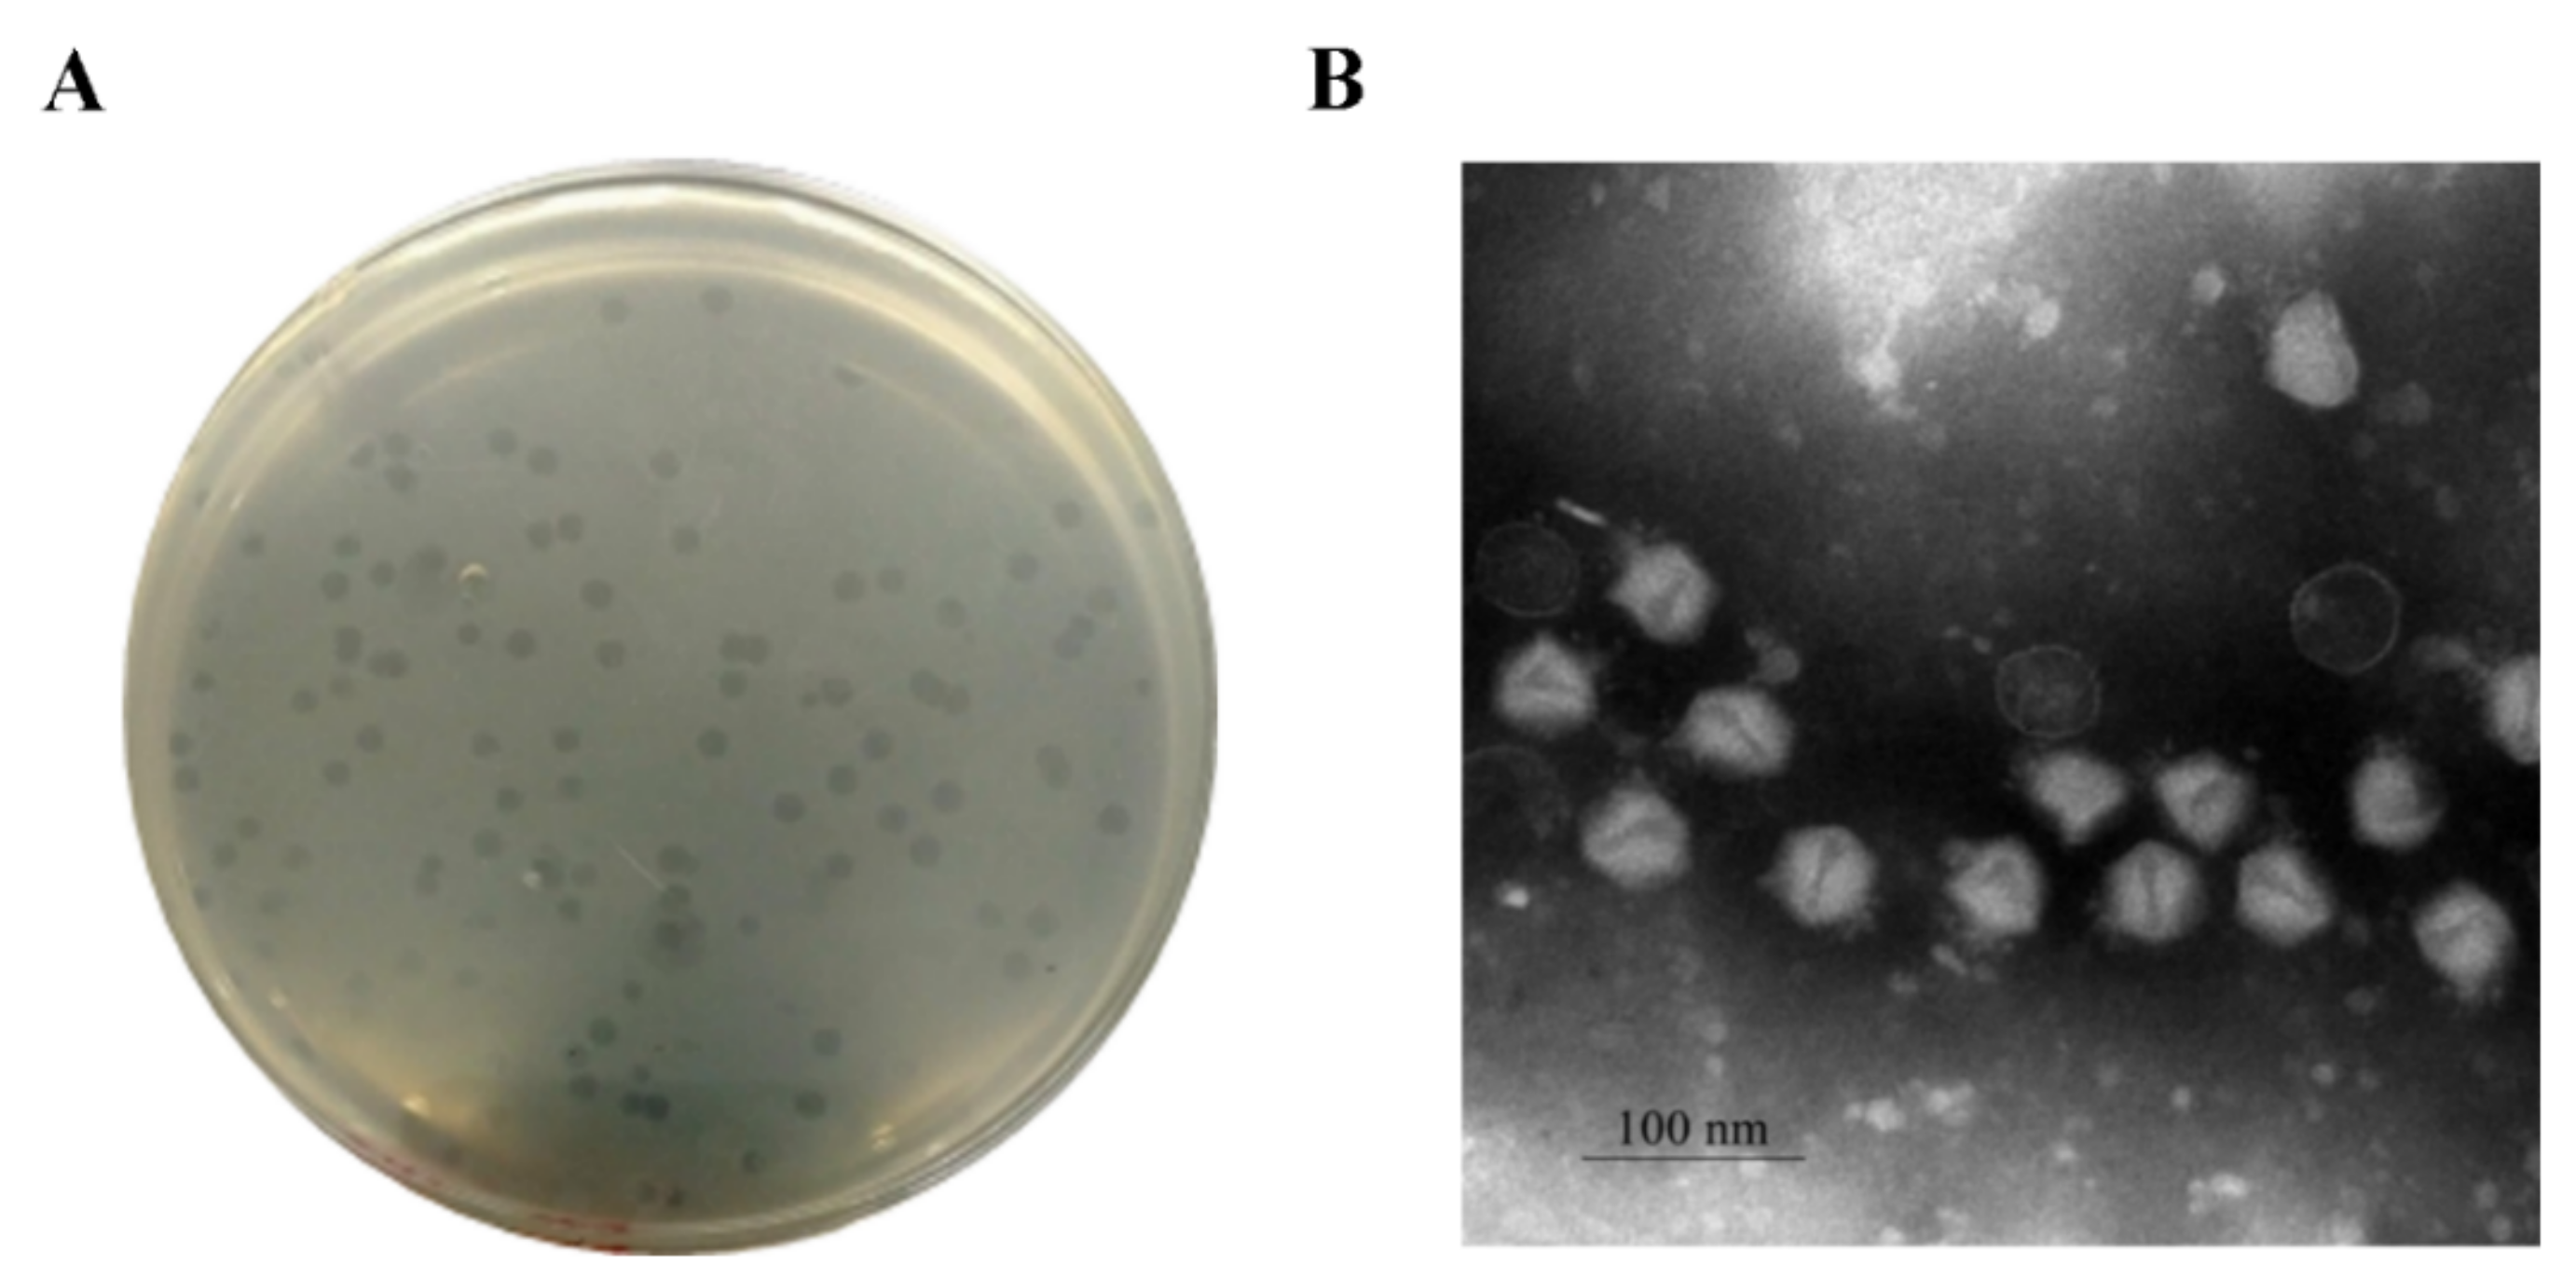
Pathogens 10 00034 g002 Pathogens 10 00034 g002

Application of a Novel Lytic Podoviridae Phage Pu20 for Biological Control of Drug-Resistant Salmonella in Liquid Eggs
Abstract
1. Introduction
2. Materials and Methods
2.1. Bacterial Strains and Culture Conditions
2.2. Enrichment, Isolation and Purification of Salmonella pullorum Bacteriophages
2.3. Host Range Study
2.4. Morphological Observation by TEM
2.5. Optimal Multiplicity of Infection
2.6. Adsorption Rate
2.7. One-Step Growth Curve
2.8. Stability of Phage Pu20 at Different Temperatures and pH
2.9. Pu20 Inhibited the Growth of MDR Salmonella enterica Serovar Enteritidis and Typhimurium
2.10. Biocontrol of Salmonella enterica Serovar Enteritidis and Salmonella enterica Serovar Typhimurium in Liquid Eggs by Pu20
2.11. Structural Protein Analysis of Pu20
2.12. Analysis of Pu20 Genome
2.13. Statistical Analysis
3. Results and Discussions
3.1. Isolation of Phages
3.2. Phage Pu20 Exhibited the Broadest Spectrum Against Salmonella
3.3. Morphology of Pu20
3.4. Optimal Multiplicity of Infection
3.5. Adsorption Rate
3.6. One-Step Growth Curve
3.7. Stability
3.8. Lytic Ability of Pu20 on MDR Salmonella Strains
3.9. Biocontrol of Salmonella enterica Serovar Enteritidis in Liquid Eggs
3.10. Biocontrol of Salmonella enterica Serovar Typhimurium in Liquid Eggs
3.11. Structural Protein
3.12. Overview of the Pu20 Genome
4. Conclusions
Supplementary Materials
Author Contributions
Funding
Institutional Review Board Statement
Informed Consent Statement
Data Availability Statement
Conflicts of Interest
References
- Haraga, A.; Ohlson, M.B.; Miller, S.I. Salmonellae Interplay with Host Cells. Nat. Rev. Genet. 2008, 6, 53–66. [Google Scholar] [CrossRef]
- Bouzoubaa, K.; Lemainguer, K.; Bell, J. Village Chickens as a Reservoir of Salmonella pullorum and Salmonella gallinarum in Morocco. Prev. Veter. Med. 1992, 12, 95–100. [Google Scholar] [CrossRef]
- Finstad, S.; O’Bryan, C.; Marcy, J.A.; Crandall, P.G.; Ricke, S. Salmonella and Broiler Processing in the United States: RelationShip to Foodborne Salmonellosis. Food Res. Int. 2012, 45, 789–794. [Google Scholar] [CrossRef]
- Dewey-Mattia, D.; Manikonda, K.; Hall, A.J.; Wise, M.E.; Crowe, S.J. Surveillance for Foodborne Disease Outbreaks—United States, 2009–2015. MMWR. Surveill. Summ. 2018, 67, 1–11. [Google Scholar] [CrossRef]
- CDC. Foodborne Diseases Active Surveillance Network (FoodNet): FoodNet Surveillance Report for 2012 (Final Report); U.S. Department of Health and Human Services, CDC: Atlanta, GA, USA, 2014.
- Kropinski, A.M.; Prangishvili, D.; Lavigne, R. Position Paper: The Creation of a Rational Scheme for the Nomenclature of Viruses Of Bacteria and Archaea. Environ. Microbiol. 2009, 11, 2775–2777. [Google Scholar] [CrossRef] [PubMed]
- Wang, S.; Duan, H.; Zhang, W.; Li, J.-W. Analysis of Bacterial Foodborne Disease Outbreaks in China between 1994 and 2005. FEMS Immunol. Med. Microbiol. 2007, 51, 8–13. [Google Scholar] [CrossRef] [PubMed]
- Braoudaki, M.; Hilton, A.C. Adaptive Resistance to Biocides in Salmonella enterica and Escherichia coli O157 and Cross-Resistance to Antimicrobial Agents. J. Clin. Microbiol. 2004, 42, 73–78. [Google Scholar] [CrossRef]
- Braoudaki, M.; Hilton, A.C. Low Level of Cross-Resistance between Triclosan and Antibiotics in Escherichia coli K-12 and E. coli O55 Compared to E. coli O157. FEMS Microbiol. Lett. 2004, 235, 305–309. [Google Scholar] [CrossRef]
- Jia, B.; Raphenya, A.R.; Alcock, B.; Waglechner, N.; Guo, P.; Tsang, K.K.; Lago, B.A.; Dave, B.M.; Pereira, S.; Sharma, A.N.; et al. CARD 2017: Expansion and Model-Centric Curation of the Comprehensive Antibiotic Resistance Database. Nucleic Acids Res. 2017, 45, D566–D573. [Google Scholar] [CrossRef]
- Staes, I.; Passaris, I.; Cambré, A.; Aertsen, A. Population Heterogeneity Tactics as Driving Force in Salmonella Virulence and Survival. Food Res. Int. 2019, 125, 108560. [Google Scholar] [CrossRef]
- Nair, D.V.T.; Venkitanarayanan, K.; Johny, A.K. Antibiotic-Resistant Salmonella in the Food Supply and the Potential Role of Antibiotic Alternatives for Control. Foods 2018, 7, 167. [Google Scholar] [CrossRef] [PubMed]
- Bajpai, V.K.; Baek, K.-H.; Kang, S.C. Control of Salmonella in Foods by Using Essential Oils: A Review. Food Res. Int. 2012, 45, 722–734. [Google Scholar] [CrossRef]
- Endersen, L.; O’Mahony, J.; Hill, C.; Ross, R.P.; McAuliffe, O.; Coffey, A. Phage Therapy in the Food Industry. Annu. Rev. Food Sci. Technol. 2014, 5, 327–349. [Google Scholar] [CrossRef] [PubMed]
- Goodridge, L.D.; Bisha, B. Phage-Based Biocontrol Strategies to Reduce Foodborne Pathogens in Foods. Bacteriophage 2011, 1, 130–137. [Google Scholar] [CrossRef] [PubMed]
- Breitbart, M.; Rohwer, F. Here a Virus, There a Virus, Everywhere the Same Virus? Trends Microbiol. 2005, 13, 278–284. [Google Scholar] [CrossRef] [PubMed]
- Garcia-Russell, N.; Elrod, B.; Dominguez, K. Stress-Induced Prophage DNA Replication in Salmonella enterica Serovar Typhimurium. Infect. Genet. Evol. 2009, 9, 889–895. [Google Scholar] [CrossRef] [PubMed]
- Kutateladze, M.; Adamia, R. Bacteriophages as Potential New Therapeutics to Replace or Supplement Antibiotics. Trends Biotechnol. 2010, 28, 591–595. [Google Scholar] [CrossRef] [PubMed]
- Bruttin, A.; Brüssow, H. Human Volunteers Receiving Escherichia coli Phage T4 Orally: A Safety Test of Phage Therapy. Antimicrob. Agents Chemother. 2005, 49, 2874–2878. [Google Scholar] [CrossRef]
- Bartholomé, K.; Kreutz, C.; Timmer, J. Estimation of Gene Induction Enables a Relevance-Based Ranking of Gene Sets. J. Comput. Biol. 2009, 16, 959–967. [Google Scholar] [CrossRef]
- El-Dougdoug, N.; Cucic, S.; Abdelhamid, A.; Brovko, L.; Kropinski, A.; Griffiths, M.W.; Anany, H. Control of Salmonella Newport on Cherry Tomato Using a Cocktail of Lytic Bacteriophages. Int. J. Food Microbiol. 2019, 293, 60–71. [Google Scholar] [CrossRef]
- Wang, C.; Chen, Q.; Zhang, C.; Yang, J.; Lu, Z.; Lu, F.; Bie, X. Characterization of a Broad Host-Spectrum Virulent Salmonella Bacteriophage Fmb-p1 and Its Application on Duck Meat. Virus Res. 2017, 236, 14–23. [Google Scholar] [CrossRef] [PubMed]
- Huang, C.; Virk, S.M.; Shi, J.; Zhou, Y.; Willias, S.P.; Morsy, M.K.; Abdelnabby, H.E.; Liu, J.; Wang, X.; Li, J. Isolation, Characterization, and Application of Bacteriophage LPSE1 Against Salmonella enterica in Ready to Eat (RTE) Foods. Front. Microbiol. 2018, 9, 1046. [Google Scholar] [CrossRef] [PubMed]
- Guenther, S.; Herzig, O.; Fieseler, L.; Klumpp, J.; Loessner, M.J. Biocontrol of Salmonella Typhimurium in RTE Foods with the Virulent Bacteriophage FO1-E2. Int. J. Food Microbiol. 2012, 154, 66–72. [Google Scholar] [CrossRef] [PubMed]
- Islam, S.; Zhou, Y.; Liang, L.; Nime, I.; Liu, K.; Yan, T.; Wang, X.; Li, J. Application of a Phage Cocktail for Control of Salmonella in Foods and Reducing Biofilms. Viruses 2019, 11, 841. [Google Scholar] [CrossRef]
- Da Silva, G.R.; Menezes, L.D.M.; Lanza, I.P.; De Oliveira, D.D.; Silva, C.A.; Klein, R.W.T.; De Assis, D.C.S.; Cançado, S.D.V. Evaluation of the Alpha-Amylase Activity as an Indicator of Pasteurization Efficiency and Microbiological Quality of Liquid Whole Eggs. Poult. Sci. 2017, 96, 3375–3381. [Google Scholar] [CrossRef]
- Meaden, S.; Koskella, B. Exploring the Risks of Phage Application in the Environment. Front. Microbiol. 2013, 4, 358. [Google Scholar] [CrossRef]
- Carey-Smith, G.V.; Billington, C.; Cornelius, A.J.; Hudson, J.; Heinemann, J.A. Isolation and Characterization of Bacteriophages Infecting Salmonella SPP. FEMS Microbiol. Lett. 2006, 258, 182–186. [Google Scholar] [CrossRef]
- Chang, H.-C.; Chen, C.-R.; Lin, J.-W.; Shen, G.-H.; Chang, K.-M.; Tseng, Y.-H.; Weng, S.-F. Isolation and Characterization of Novel Giant Stenotrophomonas Maltophilia Phage φSMA5. Appl. Environ. Microbiol. 2005, 71, 1387–1393. [Google Scholar] [CrossRef]
- Boulanger, P. Purification of Bacteriophages and SDS-PAGE Analysis of Phage Structural Proteins from Ghost Particles. Methods Mol. Biol. 2009, 502, 227–238. [Google Scholar] [CrossRef]
- Loessner, M.J.; Estela, L.A.; Zink, R.; Scherer, S. Taxonomical Classification of 20 Newly Isolated Listeria Bacteriophages by Electron Microscopy and Protein Analysis. Intervirology 1994, 37, 31–35. [Google Scholar] [CrossRef]
- López-Cuevas, O.; Campo, N.C.-D.; León-Felix, J.; González-Robles, A.; Chaidez-Quiroz, C. Characterization of Bacteriophages with a Lytic Effect on Various Salmonella Serotypes and Escherichia Coli O157:H7. Can. J. Microbiol. 2011, 57, 1042–1051. [Google Scholar] [CrossRef] [PubMed]
- Abedon, S.T. Selection for Bacteriophage Latent Period Length by Bacterial Density: A Theoretical Examination. Microb. Ecol. 1989, 18, 79–88. [Google Scholar] [CrossRef] [PubMed]
- Berngruber, T.W.; Weissing, F.J.; Gandon, S. Inhibition of Superinfection and the Evolution of Viral Latency. J. Virol. 2010, 84, 10200–10208. [Google Scholar] [CrossRef] [PubMed]
- Huang, C.; Shi, J.; Ma, W.; Li, Z.; Wang, J.; Li, J.; Wang, X. Isolation, Characterization, and Application of a Novel Specific Salmonella Bacteriophage in Different Food Matrices. Food Res. Int. 2018, 111, 631–641. [Google Scholar] [CrossRef]
- Hong, Y.; Schmidt, K.; Marks, D.; Hatter, S.; Marshall, A.; Albino, L.; Ebner, P.D. Treatment of Salmonella-Contaminated Eggs and Pork with a Broad-Spectrum, Single Bacteriophage: Assessment of Efficacy and Resistance Development. Foodborne Pathog. Dis. 2016, 13, 679–688. [Google Scholar] [CrossRef]
- Brüssow, H.; Hendrix, R.W. Phage Genomics. Cell 2002, 108, 13–16. [Google Scholar] [CrossRef]
- Gish, W.; States, D.J. Identification of Protein Coding Regions by Database Similarity Search. Nat. Genet. 1993, 3, 266–272. [Google Scholar] [CrossRef]
- Apweiler, R. UniProt: The Universal Protein Knowledgebase. Nucleic Acids Res. 2004, 32, 115D–119D. [Google Scholar] [CrossRef]
- Aziz, R.K.; Bartels, D.; Best, A.A.; DeJongh, M.; Disz, T.; Edwards, R.A.; Formsma, K.; Gerdes, S.; Glass, E.M.; Kubal, M.; et al. The RAST Server: Rapid Annotations using Subsystems Technology. BMC Genom. 2008, 9, 1–15. [Google Scholar] [CrossRef]
- Lowe, T.M.; Chan, P.P. tRNAscan-SE On-line: Integrating search and context for analysis of transfer RNA genes. Nucleic Acids Res. 2016, 44, W54–W57. [Google Scholar] [CrossRef]
- Liu, B.; Zheng, D.; Jin, Q.; Chen, L.; Yang, J. VFDB 2019: A Comparative Pathogenomic Platform with an Interactive Web Interface. Nucleic Acids Res. 2019, 47, D687–D692. [Google Scholar] [CrossRef] [PubMed]
- Grant, J.R.; Stothard, P. The CGView Server: A Comparative Genomics Tool for Circular Genomes. Nucleic Acids Res. 2008, 36, W181–W184. [Google Scholar] [CrossRef] [PubMed]
- Lavigne, R.; Seto, D.; Mahadevan, P.; Ackermann, H.-W.; Kropinski, A.M. Unifying Classical and Molecular Taxonomic Classification: Analysis of the Podoviridae Using BLASTP-Based Tools. Res. Microbiol. 2008, 159, 406–414. [Google Scholar] [CrossRef] [PubMed]
- Dereeper, A.; Audic, S.; Claverie, J.-M.; Blanc, G. BLAST-EXPLORER Helps You Building Datasets for Phylogenetic Analysis. BMC Evol. Biol. 2010, 10, 8. [Google Scholar] [CrossRef]
- Kumar, S.; Stecher, G.; Li, M.; Knyaz, C.; Tamura, K. MEGA X: Molecular Evolutionary Genetics Analysis Across Computing Platforms. Mol. Biol. Evol. 2018, 35, 1547–1549. [Google Scholar] [CrossRef] [PubMed]
- Eriksson, H.; Maciejewska, B.; Łątka, A.; Majkowska-Skrobek, G.; Hellstrand, M.; Melefors, Ã.J.; Wang, J.-T.; Kropinski, A.M.; Drulis-Kawa, Z.; Nilsson, A.S. A Suggested New Bacteriophage Genus, “Kp34likevirus”, within the Autographivirinae Subfamily of Podoviridae. Viruses 2015, 7, 1804–1822. [Google Scholar] [CrossRef]
- Lal, T.M.; Sano, M.; Ransangan, J. Isolation and Characterization of Large Marine Bacteriophage (Myoviridae), VhKM4 InfectingVibrio harveyi. J. Aquat. Anim. Heal. 2017, 29, 26–30. [Google Scholar] [CrossRef]
- Yang, Q.; Ding, Y.; Nie, R.; Yao, L.; Wang, X.; Zhou, M.; Wang, J.; Wang, X. Characterization of a novel T7-like Salmonella Typhimurium (ATCC13311) Bacteriophage LPST144 and its Endolysin. LWT 2020, 123, 109034. [Google Scholar] [CrossRef]
- Lu, Y.; Shi, H.; Zhang, Z.; Han, F.; Li, J.; Sun, Y. Isolation and Characterization of a Lytic Bacteriophage φKp-lyy15 of Klebsiella Pneumoniae. Virol. Sin. 2015, 30, 66–68. [Google Scholar] [CrossRef]
- Bao, H.; Zhang, P.; Zhang, H.; Zhou, Y.; Zhang, L.; Wang, R. Bio-Control of Salmonella Enteritidis in Foods Using Bacteriophages. Viruses 2015, 7, 4836–4853. [Google Scholar] [CrossRef]
- Li, Z.; Ma, W.; Li, W.; Ding, Y.; Zhang, Y.; Yang, Q.; Wang, J.; Wang, X. A Broad-Spectrum Phage Controls Multidrug-Resistant Salmonella in Liquid Eggs. Food Res. Int. 2020, 132, 109011. [Google Scholar] [CrossRef] [PubMed]
- Kovacs-Nolan, J.; Phillips, M.; Mine, Y. Advances in the Value of Eggs and Egg Components for Human Health. J. Agric. Food Chem. 2005, 53, 8421–8431. [Google Scholar] [CrossRef] [PubMed]
- Merrill, B.D.; Ward, A.T.; Bridgewater, L.C.; Hope, S. Software-Based Analysis of Bacteriophage Genomes, Physical Ends, and Packaging Strategies. BMC Genom. 2016, 17, 1–16. [Google Scholar] [CrossRef] [PubMed]

| Host | Total | Source Information | |
|---|---|---|---|
| Sewage | Chicken | ||
| CVCC519 | 23 | Pu1,Pu2,Pu3,Pu4,Pu5,Pu6,Pu7,Pu8,Pu16,Pu24,Pu27,Pu28,Pu29,Pu30 | Pu9,Pu10,Pu11,Pu12,Pu13,Pu14,Pu15,Pu17,Pu31 |
| CVCC534 | 11 | Pu18,Pu19,Pu20, Pu25,Pu26,Pu33,Pu34 | Pu21,Pu22,Pu23,Pu32 |
| Bacteriophage | Salmonella Indiana | Salmonella enteritidis | Salmonella typhimurium | |||||||
| 13500 | 13520 | 10960 | 11561 | 10855 | SJTUF 13306 | SJTUF 13277 | SJTUF 13336 | SJTUF 13337 | SJTUF 13350 | |
| Pu20 | ++++ | +++ | +++ | ++++ | ++ | ++ | ++++ | +++ | ++ | ++ |
Publisher’s Note: MDPI stays neutral with regard to jurisdictional claims in published maps and institutional affiliations. |
© 2021 by the authors. Licensee MDPI, Basel, Switzerland. This article is an open access article distributed under the terms and conditions of the Creative Commons Attribution (CC BY) license (http://creativecommons.org/licenses/by/4.0/).
Share and Cite
Zhang, Y.; Ding, Y.; Li, W.; Zhu, W.; Wang, J.; Wang, X. Application of a Novel Lytic Podoviridae Phage Pu20 for Biological Control of Drug-Resistant Salmonella in Liquid Eggs. Pathogens 2021, 10, 34. https://doi.org/10.3390/pathogens10010034
Zhang Y, Ding Y, Li W, Zhu W, Wang J, Wang X. Application of a Novel Lytic Podoviridae Phage Pu20 for Biological Control of Drug-Resistant Salmonella in Liquid Eggs. Pathogens. 2021; 10(1):34. https://doi.org/10.3390/pathogens10010034
Chicago/Turabian StyleZhang, Yu, Yifeng Ding, Wanning Li, Wenjuan Zhu, Jia Wang, and Xiaohong Wang. 2021. "Application of a Novel Lytic Podoviridae Phage Pu20 for Biological Control of Drug-Resistant Salmonella in Liquid Eggs" Pathogens 10, no. 1: 34. https://doi.org/10.3390/pathogens10010034
APA StyleZhang, Y., Ding, Y., Li, W., Zhu, W., Wang, J., & Wang, X. (2021). Application of a Novel Lytic Podoviridae Phage Pu20 for Biological Control of Drug-Resistant Salmonella in Liquid Eggs. Pathogens, 10(1), 34. https://doi.org/10.3390/pathogens10010034
